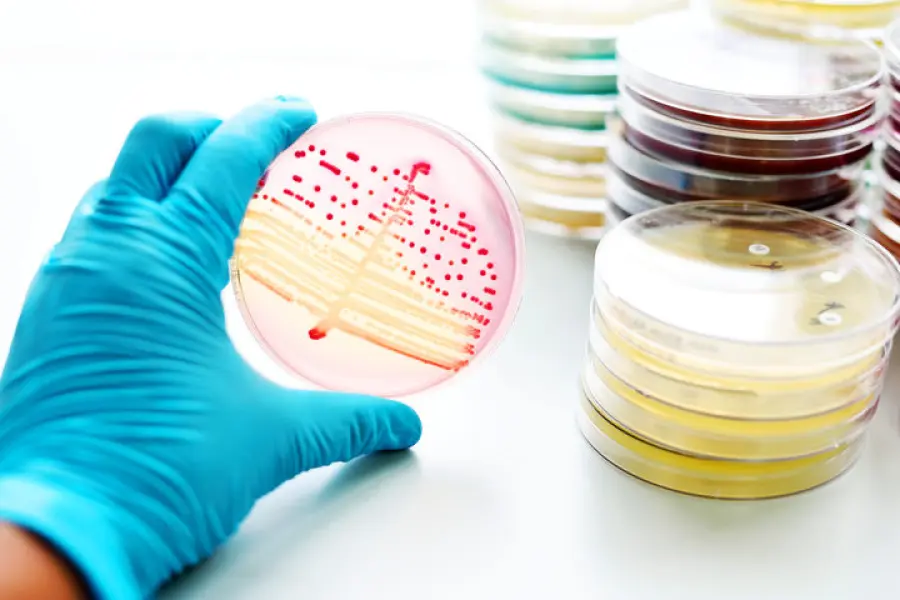
Gonorrea, allarme batterio potente: antibiotici inutili

Gonorrea, allarme batterio potente: antibiotici inutili
di Redazione

Torna la psicosi gonorrea anche in Italia. L'Oms ha reso noto che il batterio che provoca tale patologia si è rafforzato e quindi è diventato resistente agli antibiotici in circolazione. Ne deriva che la patologia è difficilmente curabile, anzi in determinati casi diventa incurabile, proprio come accadeva agli inizi del XX secolo. Sembra che il batterio della gonorrea abbia dimostrato di saper progredire e reagire efficacemente agli attuali antibiotici usati per trattare la malattia. L'Oms ha raccolto i dati relativi a 77 nazioni dove la gonorrea è alquanto diffusa. Sembra che molti studiosi siano al lavoro per creare un potente medicinale che dovrebbe contenere, in futuro, la virulenza della gonorrea. Per fortuna, la scienza fa passi da gigante e salva l'uomo.
Torna la psicosi gonorrea anche in Italia. L'Oms ha reso noto che il batterio che provoca tale patologia si è rafforzato e quindi è diventato resistente agli antibiotici in circolazione. Ne deriva che la patologia è difficilmente curabile, anzi in determinati casi diventa incurabile, proprio come accadeva agli inizi del XX secolo. Sembra che il batterio della gonorrea abbia dimostrato di saper progredire e reagire efficacemente agli attuali antibiotici usati per trattare la malattia. L'Oms ha raccolto i dati relativi a 77 nazioni dove la gonorrea è alquanto diffusa. Sembra che molti studiosi siano al lavoro per creare un potente medicinale che dovrebbe contenere, in futuro, la virulenza della gonorrea. Per fortuna, la scienza fa passi da gigante e salva l'uomo.
Come avviene il contagio?
L'uomo lavora per tutelare la salute della gente ma anche i batteri si rafforzano, come quello della gonorrea, ovvero il Neisseria gonorrhoeae. Il contagio avviene tramite contatto diretto col malato o le sue secrezioni. Solitamente, la gonorrea si trasmette mediante i rapporti sessuali. Nelle donne si manifesta con perdite dagli organi genitali, febbre, infiammazioni e nausea. Può capitare, però, che non vi siano sintomi. In questi casi la patologia non è facilmente diagnosticabile. Negli uomini, invece, la gonorrea si presenta solitamente con infiammazioni e dolore in occasione della minzione. Il medico cerca di contrastare la malattia con gli antibiotici, modalità necessaria per debellare le 'ondate' di batteri. La gonorrea non va assolutamente sottovalutata perché i suoi effetti possono essere traumatici. Molte donne, ad esempio, sono rimaste sterili; insomma, hanno dovuto rinunciare alla maternità a causa della gonorrea. Secondo i dati diffusi dall'Oms, ogni anno la gonorrea colpisce 78 milioni di persone. Il boom di casi è dovuto a ragioni diverse, come lo scarso utilizzo dei profilattici, maggior spostamenti da una parte all'altra del mondo, poche diagnosi precoci e utilizzo di antibiotici inadeguati. I primi antibiotici contro la gonorrea vennero creati negli anni '30 del XX secolo. Negli anni '80 c'erano antibiotici efficaci in circolazione contro la malattia. L'abuso delle terapie antibiotiche ha favorito il rafforzamento del batterio della patologia che, oggi, è in grado di resistere alla maggioranza degli antibiotici in circolazione. Sono necessari quindi finanziamenti alle grandi aziende per creare nuovi farmaci e antibiotici in grado di debellare i batteri super resistenti.Gonorrea tra le patologie veneree più diffuse
La gonorrea è una delle patologie veneree più diffuse e una di quelle più resistenti agli antibiotici. Questo è indubbio. Tutto ciò è un problema perché, negli ultimi anni, è aumentato il numero delle persone infettate. La gonorrea, conosciuta anche coi nomi blenorragia o scolo, occupa la seconda posizione nella classifica delle patologie veneree più diffusa al mondo: è preceduta dalla clamidia ma è davanti alla sifilide. La trasmissione dell'infezione gonococcica avviene quasi sempre mediante rapporti sessuali non protetti. Una persona viene a contatto con le mucose dell'altro o con le secrezioni. L'infezione può avvenire anche in caso di rapporti orali e anali. Inoltre, se una donna incinta è affetta da gonorrea, è probabile che la patologia venga trasmessa al bebè. E' molto difficile che il batterio possa colpire, ad esempio, con lo scambio di biancheria intima. L'eventualità, anche se rara, non è da escludere. L'attenzione, dunque, è massima davanti alla gonorrea. Gli esperti ritengono che l'habitat ideale del batterio che provoca la malattia è caldo e umido; non è un caso, dunque, che cresca e si riproduca generalmente nei genitali femminili, nell'uretra o nelle tube di Falloppio. Il batterio, comunque, può vivere e rafforzarsi, anche nelle mucose degli occhi, della bocca, del retto e della gola.Articolo Precedente
Trentaquattro candeline per Villa Ada incontra il mondo
Articolo Successivo
Sale rosa dell'Himalaya: prezzo alto per le proprietà benefiche?



